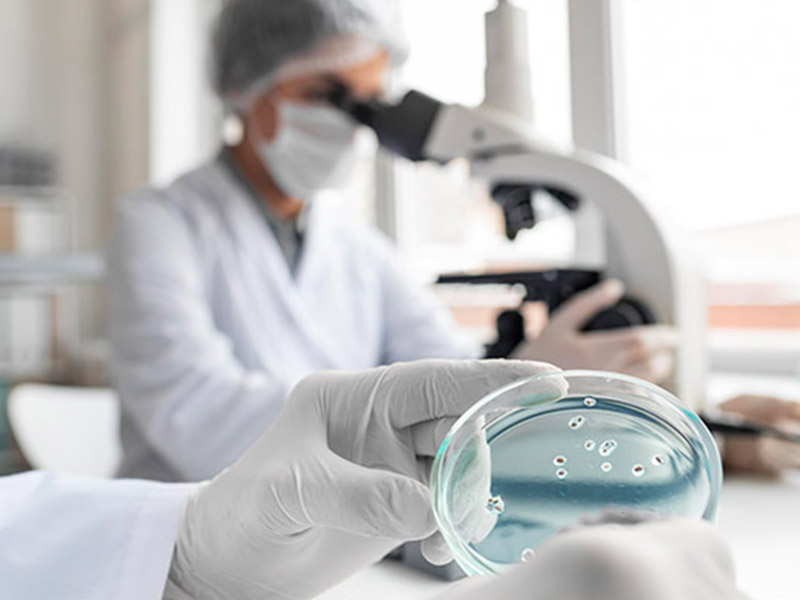

Wir fördern dringende Projekte, die von den Kassen nicht oder noch nicht finanziert werden, vorwiegend an den drei großen Hamburger Kinderkliniken.
Geförderte Projekte
Die Projekte, die „Hamburg macht Kinder gesund“ fördert, sind dringlich, innovativ, und nachhaltig - unter Berücksichtigung des Kosten-Nutzen-Verhältnisses kommen sie möglichst vielen kranken Kindern und Jugendlichen in Hamburg zugute. In den letzten 19 Jahren wurden rund 200 Projekte in der Kindermedizin von dem Verein größtenteils mit einer Anschubfinanzierung unterstützt – sowohl in der Forschung wie auch in der therapeutischen Betreuung kranker Kinder und Jugendlicher und ihrer Eltern. Dabei erwiesen sich viele der bisher geförderten Projekte in der Vergangenheit als nachhaltig so erfolgreich, dass sie in eine Regelfinanzierung überführt werden konnten.
vorherige Seite / nächste Seite | Seite 1 von 2